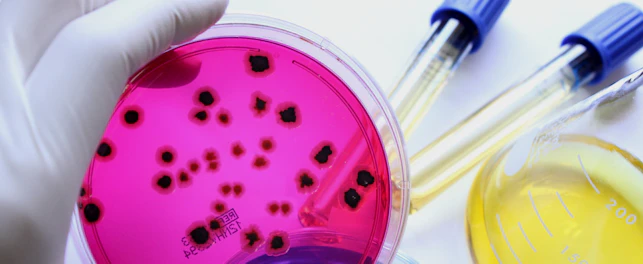
Microbes in a testing glass plate

At SGS, we are expanding our cereulide testing capacities to support clients as they manage emerging food safety risks.
Contamination in infant milk powder and baby food products can harm children and expose your business to costly recalls, regulatory action and reputational damage. A growing global food-safety concern is cereulide, a potent emetic (vomit-inducing) toxin produced by certain strains of Bacillus cereus. Our expanded, ISO-aligned cereulide‑testing solutions help you identify and manage this emerging hazard early, reinforcing your preventive food‑safety and quality-assurance programs.
Cereulide – the hidden risk in infant formula
Even when routine microbiological results meet specifications, the cereulide toxin can still be present. Unlike bacterial cells, cereulide is highly resistant to food-processing conditions, including pH changes and heat treatment. Once produced, it can remain in at-risk products even after the bacteria have been eliminated, creating a serious but often undetected safety risk.
Cereulide solutions
We provide end-to-end cereulide testing that combines ISO 7932-based ces-gene screening with an ISO 18465-aligned LC-MS/MS toxin detection service that achieves a limit of quantification (LOQ) down to 0.1 ppb. By integrating genetic screening with direct toxin analysis, we deliver a complete, high-confidence risk-management solution for cereulide, supported by fast turnaround times: four to five days for gene screening (from sample receipt to test result) and six days for cereulide toxin testing (priority option available).
Frequently asked questions
Why SGS?
- Identify and control emerging chemical and microbiological hazards
- Strengthen infant-formula and baby-food safety
- Respond rapidly and effectively to food-safety incidents and recalls
- Meet customer, regulatory and trade requirements
- Protect consumer trust and your brand reputation